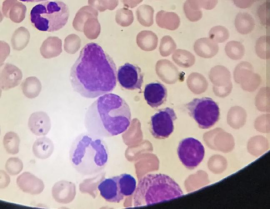
wuwei
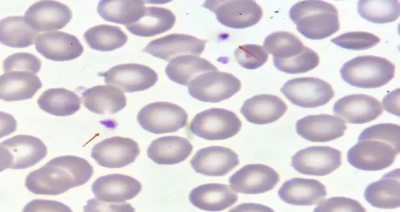
wuwei

“检”以求真 “验”以精准 ——血液病实验室项目简介
项目众多,我们该如何选择
总述
甘肃省武威肿瘤医院血液病实验室是武威市血液病检测项目覆盖最全面的实验室。实验室设置骨髓形态、细胞免疫、分子遗传、生化免疫及血栓止血五个专业学组,提供完善的血液肿瘤MICM整合诊断以及覆盖疾病诊疗全过程中的疗效及风险评估。
细胞形态学检查
血液细胞形态学检查包括外周血细胞形态学和骨髓细胞形态学检查。即将血液、骨髓液制成涂片,经过干燥、固定和染色后,在显微镜下进行分类计数。血细胞形态学是血液病基础诊断的桥头堡和侦察兵。

那些情况下需要进行血液细胞形态学检查?
第一,血液里细胞数量或者成份发生改变,包括红细胞、白细胞、血小板增多、减少或者血液中出现原始细胞;
第二,不明原因的发热、肝脏、脾脏、淋巴结肿大;
第三,不明原因的骨疼、骨质破坏、肾功能损伤。
血液细胞形态学检查对疾病的诊断、鉴别诊断有非常重要作用,是血液系统疾病诊断不可缺少的检查之一,能够为临床提供快捷准确的实验室诊断依据。
临床意义
细胞形态主要用于诊断及辅助诊断血液及其它系统疾病;判断骨髓细胞造血情况及贫血疗效;也可以帮助诊断某些代谢障碍性疾病和出血性疾病;对诊断原发或继发性骨髓肿瘤及有无恶性肿瘤骨髓转移等也有重要意义。
禁忌症
由于凝血因子缺陷引起的出血性疾病如血友病;晚期妊娠的孕妇做骨髓穿刺术应慎重。
标本采集及报告
骨髓标本大部分采用穿刺法吸取,穿刺部位选择:①骨髓腔中红骨髓丰富;②穿刺部位应浅表、易定位;③应避开重要脏器。临床上常用的穿刺部位包括胸骨、棘突、髂骨、胫骨等处。髂骨后上棘此处骨皮质薄,骨髓腔大,进针容易,骨髓液丰富,被血液稀释的可能性小,故为临床上首选的穿刺部位。
骨髓取材满意的指标:抽吸骨髓时患者有特殊的痛感;抽出的骨髓液中有较多的骨髓小粒和脂肪滴;显微镜下涂片有骨髓特有的细胞如:巨核细胞、浆细胞、造骨细胞、破骨细胞、脂肪细胞、肥大细胞、组织细胞、纤维细胞等;骨髓中中性杆状核与分叶核粒细胞之比值大于血片中的比值。

外周血细胞形态标本常用手指采血或者静脉采血(EDTA抗凝管)2ml,送检推片,当天出报告。
骨髓涂片检查收到标本后2-3天,特殊情况随时联系。
网织红细胞计数
检测内容
网织红细胞(reticulocyte,Ret,RET)是介于晚幼红细胞和成熟红细胞之间的过渡细胞略大于成熟红细胞 ,其胞质中残存的嗜碱性物质 RNA 经碱性染料(如煌焦油蓝、新亚甲蓝等)活体染色后,形成蓝色或紫色的点粒状或丝网状沉淀物。

临床意义
第一 评价骨髓增生能力,判断贫血类型;
①网织红细胞增多:表示骨髓造血功能旺盛,见于各种增生性贫血,溶血性贫血增多尤为显著。②网织红细胞减少:是无效红细胞造血的指征,见于非增生性贫血(如铁、铜、维生素 B6、维生素 B12 缺乏)慢性病性贫血(如慢性炎症、恶性肿瘤、慢性肾衰竭、再生障碍性贫血等)。
第二 评价疗效;
①观察贫血疗效:网织红细胞是贫血患者随访检查的项目之一。缺铁性贫血或巨幼细胞贫血经有效治疗 2~3 天后,网织红细胞开始上升,7~10 天达到最高峰(约 10%),2 周后逐渐降至正常水平。
②骨髓移植后监测:骨髓造血恢复:骨髓移植后第 21 天,如网织红细胞 > 15x109/L,常表示无移植并发症;若骨髓开始恢复造血功能,首先表现为 HFR 和 MFR 的升高,其次为网织红细胞升高。因此,RMI 的改变更为灵敏。
第三 放疗和化疗的监测;
网织红细胞的动态观察可指导临床适时调整治疗方案,避免造成严重的骨髓抑制。机体接受放疗、化疗后,如出现骨髓抑制,早期 HFR 和 MFR 降低,而后网织红细胞降低;停止治疗,骨髓功能恢复后,这些指标逐渐恢复。
第四 药物影响:
许多药物可引起外周血液网织红细胞变化,可导致网织红细胞假阳性的药物有解热药、氯喳、左旋多巴、奎宁等;可导致网织红细胞假阴性的有硫哗瞟吟、氯霉素、甲氨蝶吟等。
网织红细胞的效应药物:Ret>1.5%:铁剂、维生素 B12 和叶酸。Ret<0.5%:硫唑嘌呤、氯霉素、卡马西平。


参考区间
①网织红细胞比例:成年人:0.005~0.015 新生儿:0.03~0.06;儿童:0.005~0.015
②网织红细胞绝对数成年人:(24~84)×10%/L
标本采集及报告
空腹,避免溶血,EDTA抗凝2ml(紫色头管-血常规管),抽一管血
当天发出报告
红细胞寿命(CO呼气试验)
检测内容
红细胞寿命是红细胞破坏增加的定量指标,能反映会导致红细胞破坏增加的各种疾病病情,与胆红素、网织红等其它反映红细胞破坏增加及代偿增生类指标相比,具有敏感、及时、精准这三大突出优势,正常寿命70-140天。

临床应用
1)溶血的诊断及鉴别诊断:
溶血不是一个独立疾病,任何原因引起溶血都表现为RBCS测定值缩短,RBCS缩短是反映溶血最直接、最可靠的指标,亦可定量反映溶血程度。适用于各种疾病合并贫血的诊断及鉴别诊断:如严重感染、自身免疫紊乱、恶性肿瘤等合并贫血、药物(如利巴韦林、抗肿瘤化疗药物等)相关贫血、治疗(如放射治疗、血液透析、心脏瓣膜置换等)相关贫血等,若RBCS测定值<50d,提示溶血是介导此类疾病贫血发生的主要机制。
2)贫血发病机制的研究:
灵敏的RBCS测定辅助临床鉴别贫血发病机制中的不显著亚临床溶血状态,有助于指导治疗,如再生障碍性贫血、肾性贫血、噬血细胞综合征贫血、骨髓增生异常综合征贫血、淋巴瘤贫血、白血病贫血、炎症性贫血等。若RBCS测定值<50d,提示溶血参与此类疾病进展,治疗措施要兼顾控制溶血发生会取得更好疗效。
3)红细胞增多症鉴别:
红细胞寿命缩短见于真性红细胞增多症、慢性缺氧继发红细胞增多症,而EPO分泌增多的继发红细胞增多症则红细胞寿命正常。
4)孤立性高胆红素血症鉴别诊断:
RBCS测定能早期灵敏提示不典型的轻微溶血,可鉴别源于肝病(如Gilbert综合征)或溶血,提供了可靠的实验室依据,可助之尽早明确诊断。
5)溶血性疾病疗效判断及早期预测复发
RBCS可作为抗溶血治疗疗效观察的重要指标,尤其动态检测同一患者的RBCS,较目前其他指标可以早期反映溶血发生及程度。适用于溶贫治疗期间的疗效评估、溶血复发的早期识别等。


使用人群
各类贫血或长期贫血、体重骤降、胆红素升高、肝肾功能异常、红细胞增多及体检等。
注意事项
消化道出血、剧烈运动、熬夜、感染等可造成红细胞破坏一过性增加,即红细胞寿命一过性缩短;服用某些药物会使短期内红细胞破坏速率不稳定。咨询、了解受试者试验前的生理、病理状况及服药情况,便于对RBCS变化原因的综合判断。
标本采集及报告
空腹,最好清晨起床后至上午12点前采气,避免剧烈运动后采气(应在静息状态下进行采气操作);受试者采气前一周内未输红细胞,24h内不能主动或被动吸烟;另需患者提供当日血红蛋白的数值。
病人到1号楼3楼血液病实验室采集气袋,当天20-30分钟出报告。
内源性、外源性凝血因子

检测内容
血浆与组织中直接参与凝血的物质,统称为凝血因子。分为内源性凝血因子(VIII、Ⅸ、Ⅺ、Ⅻ)和外源性凝血因子(Ⅱ、V、Ⅶ、Ⅹ)

使用人群
血友病、各类凝血功能异常、不明原因出血等患者。
标本采集及报告
空腹,避免溶血,枸橼酸钠抗凝2ml(蓝色头管-凝功管),可抽一管血。
当天收到标本后30-40分钟发出报告。

淋巴细胞免疫分析(T.B/NK淋巴细胞亚群)
检测内容
人体免疫可以从三个层面进行探讨:免疫系统、免疫细胞和免疫分子。而在免疫细胞中,由T细胞、B细胞和NK细胞组成的淋巴细胞谱系,与以中性粒细胞、单核细胞为代表的髓样细胞谱系各占半壁江山,共同抵抗外界对人体的侵袭。

淋巴细胞包括T细胞、B细胞、NK细胞等。T细胞主要参与细胞免疫,表达CD3抗原,其中,T细胞又包括辅助T细胞(Th)和抑制T细胞(Ts),它们分别表达CD4和CD8。B细胞主要参与体液免疫,表达CD19抗原;NK细胞表达CD16和/或CD56,在机体中不依赖抗原刺激自发地发挥细胞毒效应。
临床意义
评价肿瘤患者的免疫功能,评估放化疗的疗效,判断预后,预测肿瘤复发风险,根据患者淋巴细胞亚群检测结果,及时调整治疗方案,以便达到更好的治疗效果;免疫缺陷病疗效评判;自身免疫性疾病和移植后的免疫监测都有重要的辅助诊断作用
什么人适合进行淋巴细胞亚群检测
原则上来讲,在机体的免疫(防御、自稳、监视)功能受损的情况下要考虑检查淋巴细胞亚群,下面列出了一些常见情况:
(1)免疫防御功能受损(2)免疫自稳和耐受功能受损(3)免疫监视功能受损(肿瘤性改变)(4)其他特殊情况(血常规中淋巴细胞明显异常、家族免疫缺陷病史、长期使用免疫抑制剂)

注意事项
①空腹或餐后两小时进行采血。
②采血后轻轻颠倒混匀5-10次,禁止剧烈摇晃采血管。
③不要拍打患者手臂进行采血,止血带不应扎得太紧,时间最好不超过2min,采血应顺利,以防溶血。溶血、血液凝固的血样均严重影响结果,不能用于检测。
标本采集及报告
空腹,避免溶血,EDTA抗凝2ml(紫色头管-血常规管),抽一管血
每周一、三、五之前收集标本,17:00后发出报告。
HLA-B27(人类白细胞分化抗原B27)

检测内容
简单地说,HLA-B27是人类白细胞抗原B27的简称,为遗传标记物,存在于人体细胞核里面的遗传物质DNA的一部分。简单通俗的理解:HLA-B27就像人的血型一样,出生时就决定了,它有遗传特性,一旦查出是阳性,就说明这个人的基因具有这种特征,就不可能再转变成阴性了。
HLA-B27与强直性脊柱炎是什么关系?
早在1973年,Brewerton和Schlosstein两位教授就证实了B27与强直性脊柱炎之间存在很强的关联性。B27与强直性脊柱炎的联系是迄今已知的HLA与疾病的关联中最强和最典型的一种。许多研究显示强直性脊柱炎患者中B27的阳性率高达90%以上。而正常人群中仅仅为4-7%,并且HLA-B27阳性的人群发生强直性脊柱炎的机会是HLA-B27阴性人群的100倍以上。

(HLA-B27阳性与强直性脊柱炎包含关系示意图)
HLA-B27阳性一定是“强直”吗?
不一定。目前中国人群B27的阳性率为2%-8%,而强直的发病率为0.3%,B27检测的阳性率大于强直的发病率。因此许多HLA-B27阳性的人不是AS。因此HLA-B27阳性不能确诊强直性脊柱炎,阴性也不能完全排除强直性脊柱炎。
由于强直性脊柱炎一般都为良性过程,但有部分患者可受遗传因素的影响,以致于病情进展较快,很有可能导致畸形。其病变由最初的腰骶椎疼痛上升到胸椎,最后还可能上升到颈椎。最终导致脊柱强直、关节畸形、病情不可逆转的残疾等。所以说早发现、早治疗,对于强直性脊柱炎的早期治疗来说是极为重要的。

哪些人需要检测HLA-B27?
1)有强直性脊柱炎家族史人群;
2)有腰背部疼痛和僵硬等主要症状,以休息后加重和活动后缓解为主要特征的人群;
3)有颈、胸、腰背、臀部、髋关节等全身多处疼痛肿胀的人群;
4)有脊柱驼背畸形和脊柱强直的人群;
5)有突发眼痛、眼红、畏光、流泪等症状的人群;
6)皮肤有银白色鳞屑并伴有手足小关节、腕关节受累或中枢关节受累;
7)体检人群。
标本采集及报告
无需空腹,避免溶血,EDTA抗凝2ml(紫色头管-血常规管),抽一管血
每周一、三、五之前收集标本,17:00后发出报告。
血清蛋白电泳、免疫固定电泳(血、尿)
检测内容
一 、血清蛋白电泳
1. 原理:血清中的蛋白质在缓冲液中,由于蛋白分子大小以及带电量的不同,因为迁移速率不同,血清蛋白会分为五个主要区带:


2. 适用人群:
1)40岁以上的中老年人;
2)MM患者的一级亲属;
3)MGUS或SMM患者;
4)不明原因高钙;
5)自身免疫性疾病患者;
6)生化检查中球蛋白升高的患者;
7)不明原因的疼痛或反复骨折的患者;
8)不明原因贫血或者贫血程度和肾损害程度不平行;
9)不伴血尿和高血压的NS,或肾脏病早期就出现贫血和肾衰竭。
二 免疫固定电泳
1. 原理:血清蛋白或者尿蛋白在凝胶介质中分六个泳道进行电泳分离,然后每个泳道加入不同的抗体或固定液(依次为免疫固定液、γ重链、α重链、μ重链、κ轻链、λ轻链抗血清)与蛋白质结合发生抗原抗体反应,清洗掉未结合蛋白后进行染色。

2. 临床应用
对M蛋白进行分型和鉴定的意义
①判断M蛋白类型与疾病:
单克隆的IgG,IgA,IgD,轻链常见于多发性骨髓瘤;
单克隆IgM常见于华氏巨球蛋白血症。
②多发性骨髓瘤分期:
StadeIII:血清内高浓度单克隆IgG >70 g/L 或 IgA > 50 g/L。
③评估MGUS和无症状型骨髓瘤(SM) 的恶化风险:
IgM或IgA MGUS 比IgG MGUS的风险要高;
IgA SM 病情发展比IgG SM更严重。
为什么要做尿免疫固定电泳?
某些情况下,特别是对轻链型的M蛋白,尿免疫固定电泳比血清免疫固定电泳更加敏感。因为游离轻链的分子量更小(25-50KD),容易透过肾脏进入尿液中,从而在尿中被检测到。
注意事项
1、溶血标本:在γ区会出现血红蛋白条带。
2、陈血标本:由于IgG的聚合,会出现窄区带。
3、血浆标本:在ELP条带会出现纤维蛋白原条带。
4.送检尿液免疫固定蛋白电泳分析项目,要求病人留取清洁中段晨尿,以提高检出率;
5.静脉输注血管扩容剂、明胶类血浆代用品(如Plasmion或Gelofusine)或免疫球蛋白,可影响尿蛋白电泳结果,建议临床用药后2-3天再采集尿液送检;
6.切忌将采集的抗凝全血再次倒入红帽真空采血管中。
标本采集及报告
血清:空腹,避免溶血,生化管3-5ml(黄色头管),可抽一管血;
尿液:3-5ml
每周四之前收集标本,周四16:00后发出报告。


抗血小板膜蛋白抗体
检测内容
抗血小板糖蛋白特异性自身抗体检测
抗血小板膜糖蛋白特异性自身抗体主要是针对血小板膜表面糖蛋白Ⅱb~Ⅲa(GPⅡb~Ⅲa)、膜糖蛋白I b(GPIb)、膜糖蛋白IX(GPIX)抗原等产生相应的血小板抗体。相应血小板抗体结合到血小板表面,引起血小板致敏,从而被单核一巨噬系统破坏。

临床意义
辅助诊断免疫性血小板减少症:指南推荐。
鉴别诊断继发性免疫性血小板减少症和非免疫性:①化疗药物可导致药源性的免疫性血小板减少症。已有报道显示,反复应用奥沙利铂可诱导并维持免疫反应,从而导致免疫性血小板减少症。②感染:EBV和HCMV。③血液病患者免疫机制异常:AA
避免输血不良反应:有效避免免疫因素所致的血小板输注无效。
指导临床用药
适用人群
所有血小板减少患者。
标本采集及报告
空腹,避免溶血,EDTA抗凝2ml(紫色头管-血常规管),5项抽一管血
每周三之前收集标本,周三16:00后发出报告。
肿瘤伴随诊断因子检测
检测内容
TGF-α/TGF-β1/CXCL12/VEGF/GM-CSF/G-CSF联合检测。可动态监测肿瘤发生、迁移、浸润以及预后,为临床提供更多患者免疫信息。
临床意义
转化生长因子α TGF-α:GF-α属EGF家族,是目前被广泛研究的表皮生长因子受体(EGFR)配体,与促进肿瘤发生、转移、耐药相关。
转化生长因子β1 TGF-β1:TGF-β1是人体多种上皮起源细胞的生长调节因子,对多种细胞具有调控作用。在肿瘤发生过程中起着双向调节,与肿瘤进展、浸润及转移相关。
趋化因子配体12 CXCL12:又称基质细胞衍生因子1(SDF-1)是小分子的细胞因子,属于趋化因子蛋白家族。与肿瘤迁移相关,高表达CXCL12诱导肿瘤定向迁移。
血管内皮生长因子VEGF:VEGF是一种具有高度生物活性的功能性糖蛋白。它是特异性的、生理作用强大的内皮细胞有丝分裂原,参与血管生成并使毛细血管通透性增加。
粒细胞-巨噬细胞集落刺激因子GM-CSF主要由T细胞和巨噬细胞产生,能够诱导粒细胞前体和巨噬细胞前体细胞呈集落生长。促进髓样细胞增殖分化,抑制LPS诱导DCs成熟,影响肿瘤微环境,促进免疫逃逸,加速进展。
粒细胞集落刺激因子G-CSF:G-CSF主要由内毒素、TNF-a和IFN-γ活化单核细胞和巨噬细胞产生,刺激中性粒细胞存活时间延长,提高吞噬活性。参与机体免疫,提高中性粒细胞系造血细胞的增殖、分化和活化。
适用人群
肿瘤患者、健康人群肿瘤筛查
标本采集及报告
空腹,避免溶血,EDTA抗凝2ml(紫色头管-血常规管),抽一管血
每周三之前收集标本,周三17:00后发出报告。
实验大厅




开单科室:血液病实验室
送检地址:重离子一号楼3楼血液科 血液病实验室
联系人:郭发慧13809352850 赵海涛18298335009

血液科简介
甘肃省武威医学科学院血液科下设血液病病房、造血干细胞移植病区、血液病实验室及武威血液病研究所,四个亚学科,开放床位50张。2019年入选全国首批儿童血液病和恶性肿瘤诊疗协作组成员单位,2021年5月被评为武威市重点学科。2023年加入西北血液病专科联盟、甘肃省 白血病 临床医学研究中心分中心、西北四省慢淋工作组成员单位,2024年2月被中华医学会血液分会血栓与止血组评定为ITP全程管理质量提升项目培育中心。2024年8月被评为全市优秀医师团队。现有副主任医师 1 名,主治医师 2 名,实验室主管检验师 1 名,住院医师 4 名,护理人员 11 名。科室主要开展造血干细胞移植术(包括自体移植和异体移植)、血细胞分离技术、骨髓穿刺术、骨髓活检术、腰椎穿刺+鞘内注射术、PICC置管技术、PICC及CVC的维护技术、输液港维护技术、血液病急危重患者抢救技术等。对白血病、 淋巴瘤 、 多发性骨髓瘤 、 再生障碍性贫血 、 骨髓增生异常综合症 等疾病的诊疗达到河西领先水平。在血液病的诊断、治疗及疗效评判上已形成显著的专科优势。传承临床血液病学和实验相结合的发展方向,运用流式细胞仪、凝血因子分析仪、红细胞寿命测定仪、琼脂糖凝胶电泳仪、Olympus光学显微镜、免疫组织化学法等技术对各种常见血液病进行诊断与分型,在河西地区率先引进了血液分子生物学、细胞生物学、血液免疫学、细胞遗传学和细胞形态学等血液病诊断先进技术,按照国际、国内标准对各种血液病进行诊断和疗效判断。

学科带头人王聪
●甘肃省武威肿瘤医院血液科主任
●中国康复医学会血液病康复专业委员会青年工作组第一届青委
●中国研究型医院学会血液精准诊疗专业委员会委员
●中国人体健康科技促进会 淋巴瘤 专业委员会委员
●中国肿瘤防治联盟首届甘肃省联盟淋巴瘤专业委员会常委
●甘肃省抗癌协会血液病转化医学专业委员会第一届委员会常委
●甘肃省血液病质量控制中心专家
●甘肃省医师协会血液科医师分会委员会常委
●甘肃省中西医结合学会第一届血液病专业委员会常委
●陕西省研究型医院学会细胞专业委员会委员
●甘肃省抗癌协会淋巴瘤专业委员会第二届委员会委员
●甘肃省医师协会整合医学医师分会血液病专业委员会委员
●武威市医学会血液病专业委员会副主委
●武威市中西医结合学会第一届血液病专业副主委
●武威市血液病质量控制中心专家
●人民好医生(淋巴瘤领域)优秀典范专家